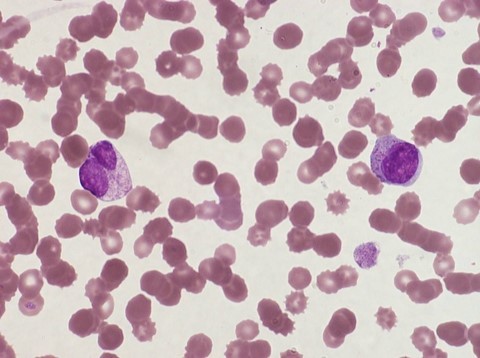

What can leukaemia be?
Acute/ Chronic
Myeloid/ Lymphoid
What is acute leukaemia?
A neoplastic condition characterized by
Rapid onset
Early death if untreated
Immature cells (blast cells)
Bone marrow failure
Anaemia: fatigue, pallor, breathlessness
Neutropenia: infections
Thrombocytopenia: bleeding
Which cells does AML, CML, B-ALL, T-ALL and CLL affect?

Which cell is dominant in acute leukaemia?
Blast cells
What is the age people get AML?
Incidence increases with age- median = 65-70 yrs
How may chromosomes be different in AML?
Chromosome abnormalities include:
What are important anomalies?
t(15;17)
t(5;8)
inv(16)
What do inversions and translocations cause in leukaemia?
•Altered DNA sequence
–creation of new fusion genes (AML and ALL)
–abnormal regulation of genes (mainly ALL)
What is duplication common in?
–+8
–+21 gives predisposition
•Possible dosage affect
–extra copies of proto-oncogenes
What is chromosomal loss and deletion important to?
–deletions and loss of 5/5q & 7/7q
What Molecular abnormalities in patients with apparently normal chromosomes are common?
Don’t need details
Why do blast cells accumulate?
There is a block in maturation
Blast cells accumulate
Why do people get AML?
What is leukaemogenesis in AML?
•Multiple genetic hits
–at least 2 interacting molecular defects
–synergise to give leukaemic phenotype
What are type 1 and type 2 abnormalities in leukaemogenesis in AML?
•Type 1 abnormalities
–promote proliferation & survival
•Type 2 abnormalities
–block differentiation (which would normally be followed by apoptosis)
Anti-apoptosis and pro-proliferation
Blocking differentiation and maturation
Anti-apoptosis and pro-proliferation
Blocking differentiation and maturation
How does differentiation work?
•Transcription factors
–bind to DNA
–alter structure to favour transcription
–regulate gene expression
•If transcription factor function is disrupted, cells cannot differentiate
What is core bidning factor?
•Core binding factor
–dimeric transcription factor
–master controller of haematopoiesis
What are the Core Binding Factor Leukaemias?
•t(8;21) fuses RUNX1 (encoding CBFα) with RUNX1T1
–15% of adult AML
•inv(16) fuses CBFB with MYH11
–12% of adult AML
What is t(8;21)?
With this particular chromosomal abnormality there is some maturation; these are not all blast cells

What does inv(16) do?
Again, in this genetic subtype there is some maturation to bizarre eosinophil precursors with giant purple granules
What is Acute promyelocytic leukaemia with t(15;17)?
The block in maturation is later
What is this and how is it different to the variant form?

t(15;17) classical
Variant looks like this but basic molecular mechanism is the same.
Summarise leukaemogenesis in AML
•Transcription factor dysregulation
–not sufficient alone to cause leukaemia
–further genetic hits are required